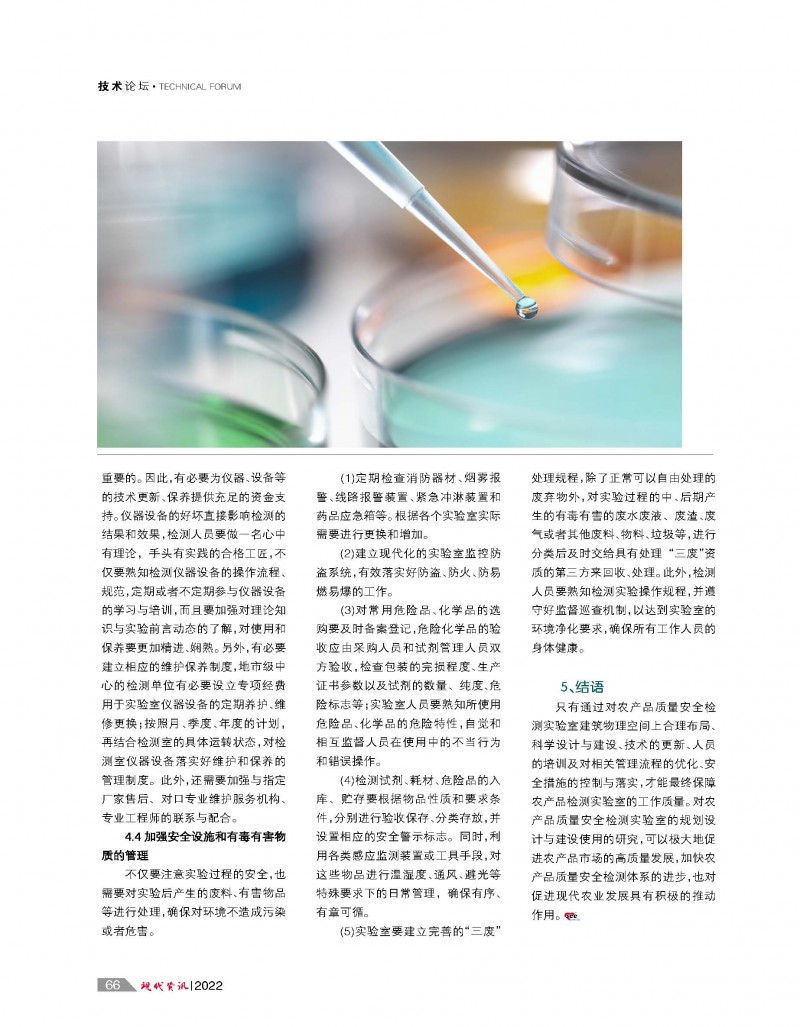

本刊優(yōu)勢(shì):
1、信息類雜志創(chuàng)刊時(shí)間最早(2000年元月創(chuàng)刊),擁有一定固定的客戶源和讀者群;
2、定位明確,發(fā)行對(duì)象極具針對(duì)性,產(chǎn)品分類精細(xì),專業(yè)性強(qiáng),廣告效果顯著(2005年4月全新改版);
3、非純商情雜志,內(nèi)容可讀性強(qiáng),聘請(qǐng)了一批實(shí)驗(yàn)室行業(yè)的專家為顧問(wèn),提供技術(shù)支持;
4、本刊管理人員從事實(shí)驗(yàn)室產(chǎn)品銷售工作多年,對(duì)實(shí)驗(yàn)室市場(chǎng)的理解和把握有一定的見解;
5、采取“網(wǎng)、刊、會(huì)”結(jié)合的形式,立體式服務(wù),全方位宣傳,性價(jià)比高(2005年3月推出VIP會(huì)員服務(wù));
6、2004年10月先后設(shè)立上海、北京、廣州信息服務(wù)網(wǎng)點(diǎn),完善服務(wù)體系,使我們的服務(wù)在最短時(shí)間內(nèi)傳遞給您及您的目標(biāo)客戶;
7、2006年隆重推出電子版、光盤版合訂本,多元化有效發(fā)行。
8、2015 年元月【現(xiàn)代資訊】微信訂閱號(hào)(msee2000)上線并推廣 。
9、2017年元月【現(xiàn)代資訊】網(wǎng)站全新上線(http://www.wyzto.cn/);同時(shí)推出電子期刊微信版。
10、2017年元月【現(xiàn)代資訊】現(xiàn)代實(shí)驗(yàn)室裝備網(wǎng)PC站、手機(jī)站全新改版上線(http://m.Lab168.cn); 紙媒、網(wǎng)站與移動(dòng)全方位推廣。
8、2015 年元月【現(xiàn)代資訊】微信訂閱號(hào)(msee2000)上線并推廣 。
9、2017年元月【現(xiàn)代資訊】網(wǎng)站全新上線(http://www.wyzto.cn/);同時(shí)推出電子期刊微信版。
10、2017年元月【現(xiàn)代資訊】現(xiàn)代實(shí)驗(yàn)室裝備網(wǎng)PC站、手機(jī)站全新改版上線(http://m.Lab168.cn); 紙媒、網(wǎng)站與移動(dòng)全方位推廣。
精確細(xì)分 精細(xì)發(fā)行 精致服務(wù) 鄭重承諾
為進(jìn)一步提升發(fā)行服務(wù)質(zhì)量,讓廣大合作伙伴能夠“更精確、更全面、更及時(shí)”把自己的信息傳遞到目標(biāo)客戶中,《現(xiàn)代資訊》作出鄭重服務(wù)承諾:
如果您的目標(biāo)客戶沒有看到《現(xiàn)代資訊》,請(qǐng)給我們提供線索,我們承諾在當(dāng)月就一定會(huì)把我們的網(wǎng)刊投遞到他(她)們的手中。